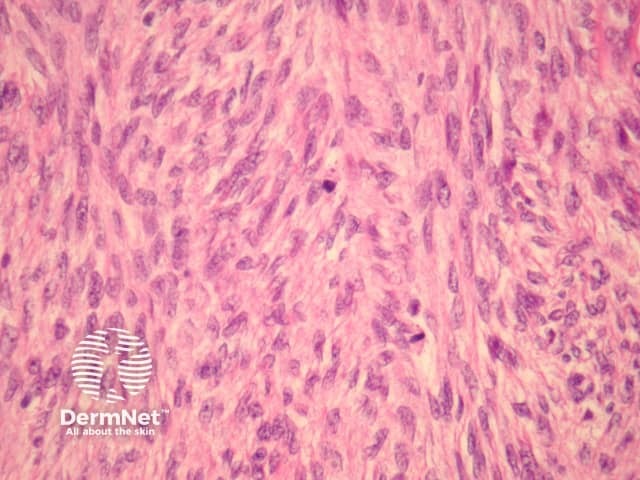
Figure 4

Main menu
Common skin conditions
NEWS
Join DermNet PRO
Read more
Quick links
Lesions (cancerous) Diagnosis and testing
Author: Assoc Prof Patrick Emanuel, Dermatopathologist, Auckland, New Zealand, 2013.
Fibrosarcoma was diagnosed far more frequently before the advent of immunohistochemical studies. It is currently thought to account for less than 1% of all adult sarcomas. These tumours may arise de novo or within another sarcoma.
In fibrosarcoma, sections show a dermal (figure 1) or subcutaneous spindle cell tumour. The tumour may arise de novo or in association with another sarcoma. Figure 2 shows a fibrosarcoma (left) arising within a dermatofibrosarcoma protuberans (right) with arrows delineating the margin.
The tumour is composed of relatively uniform spindled cells which are deeply basophilic (figures 2-4). Characteristically, the malignant cells are arranged in a “herringbone” pattern (best seen in figure 3). Mitoses are usually easy to find (figure 4).
Two distinct variants exist: the infantile variant and the sclerosing epithelioid variant. Fortunately, these variants are extraordinarily rare in the skin.

Figure 1

Figure 2

Figure 3
Figure 4
An extensive immunohistochemical panel is essential to rule out other malignant tumours. The tumour is negative with S100 (essentially excluding melanoma), keratins (excluding carcinoma and synovial sarcoma), smooth muscle markers (excluding leiomyosarcoma), CD34 (excluding dermatofibrosarcoma protuberans).
Immunohistochemical studies are essential to exclude other sarcomas (see above).